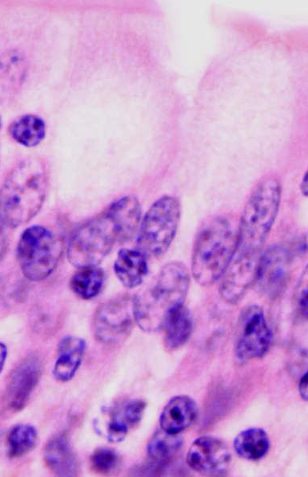
<p>naam structuur</p>
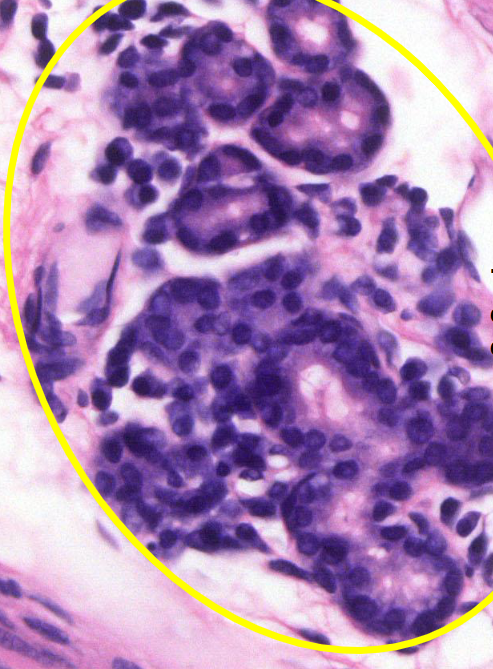
<p>structuur en soort epitheel</p>
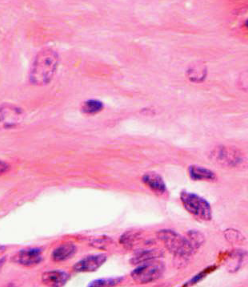
term image

1/84
Looks like no tags are added yet.
Name | Mastery | Learn | Test | Matching | Spaced | Call with Kai |
|---|
No analytics yet
Send a link to your students to track their progress

ascaris

celcultuur

welk preparaat en kleuring
pylorus maag hond
HE

benoem onderdelen


welk soort weefsel
eenlagig cilindrisch slijlmnapepitheel

naam weefsel rechts onder
bindweefsel

welk preparaat en kleuring?
pylorus maag hond
pas kleuring

welk soort weefsel?
slijmnapepitheel

preparaat en kleuring
fundus lebmaag HE

preparaat en kleuring
fundus lebmaag pas

welk soort weefsel en welk preparaat
slijmvliesepitheel
lebmaag rund HE

welke structuur?
fundusklieren

duid eosinofiel en basofiel aan


naam structuur
vene

naam structuur
slijmnap

preparaat en kleuring
dunne darm varken HE

duid vilus, plican crypten en lumen aan


soort weefsel
epitheel: 1 lagig cilindrisch
naam structuur
slijmbekercel

preparaat en kleuring
eileider rund HE

welke weefsels


soort epitheel
pseudo-tweelagig cilindrisch epitheel

benoem structuren


wat te zien
mesotheel thv ophangbanden en buitenste laag eileider

welke structuur
endotheel bloedvaten

preparaat en kleuring
ductus epididymidis ram HE

benoem structuren


welk weefsel
epitheel ductus epididimidis

naam epitheel
pseudo tweelagig epitheel

welke structuur (macro)
ductus deferens

naam structuur
arterie

endotheel

preparaat en kleuring
trachea konijn HE

benoem structuren


soort epitheel
respiratoir epitheel= pseudo meerlagig trilhaarepitheel met slijmbekercellen
structuur en soort epitheel
tracheaalklieren
eenlagig kubisch epitheel

endotheel

preparaat en kleuring
trachea konijn pas

wat kleurt pas positief
slijmbekercellen en kraakbeen

preparaat en kleuring
urether rund HE

welke weefsels


soort cellen


endotheel bloedvat

preparaat en kleuring
overgang slokdarm maag hond HE

welke structuur op iedere streep


welk epitheel
meerlagig onverhoornd plavei epitheel

naam strepen
-stratum superficiale
-stratum spinosum=stratum intermedium
-stratum basale

structuur?
muceuze slokdarm klieren

soort epitheel
tweelagig kubisch epitheel

soort epitheel en structuur
eenlagig cilindrisch epitheel
muceuze slokdarmkliereindstukken=glandulae oesophagei

soort epitheel
eenlagig afgeplat epitheel
mesotheellaagje

foveolae= infundibulae

fundusklieren

basofiel en eosinofiel



preparaat en kleuring
overgang slokdarm maag hond pas

pas positief?
muceuze slokdarmklieren: ++
basaalmembraan: +

muceuze slokdarmklieren

slijmnappen++

preparaat en kleuring
tong hond HE

soort epitheel
kegelvormig plavei epitheel

soort epitheel
meerlagig verhoornd plavei epitheel

soort weefsel
bindweefsel

pijl
endotheelkern

soort epitheel
meerlagig onverhoornd plavei epitheel



preparaat en kleuring
tepel rund HE

soort epitheel
meerlagig verhoornd plavei epitheel

stratum spinosum
stratum basale

stratum granulosum

stratum corneum

soort epitheel
meerlagig verhoornd plavei epitheel

melkklier alveoli

soort epitheel
tweelagig cilindrisch epitheel: basale en apicale celrij



epitheel
eenlagig kubisch epitheel

ooglid rund HE

tarsaalklier= klier van Meimobius

epitheel
meerlagig verhoornd plavei epitheel
buitenzijde ooglid

epitheel
meerlagig onverhoornd plavei epitheel
binnenzijde ooglid

holocriene secretie

epitheel
afvoerweg
meerlagig verhoornd plavei epitheel

apocriene zweetklier

epitheel
eenlagig kubisch epitheel